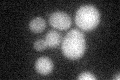
YOR278W
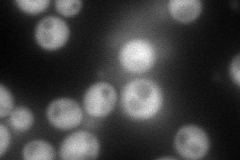
YOR278W
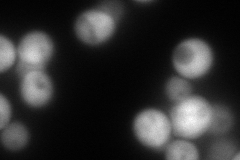
YOR278W
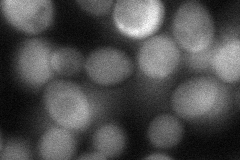
YOR278W

View description
Uroporphyrinogen III synthase, catalyzes the conversion of hydroxymethylbilane to uroporphyrinogen III, the fourth step in heme biosynthesis; deficiency in the human homolog can result in the disease congenital erythropoietic porphyria
Localization:
Intensity:
Fold change:
Significance:
-
C’ GFP library in SD
below threshold18.76 -
N' NOP1pr-GFP in SD
cytosol123.77 -
N' TEF2pr-mCherry in SD
cytosol195.696 -
N' NATIVEpr-GFP in SD

cytosol21.1972 -
N' TEF2pr-VC and Cyto-VN in SD
cytosol55.6955 -
C’ GFP library in SD+DTT

cytosol21.451.14No -
C’ GFP library in SD+H2O2

cytosol21.221.13No -
C’ GFP library in Starvation Media

cytosol17.570.93No -
C’ GFP library on the background of Pup2-DaMP

below threshold -
C’ GFP library on the background of CCT mutant

below threshold21.78291.16064No
